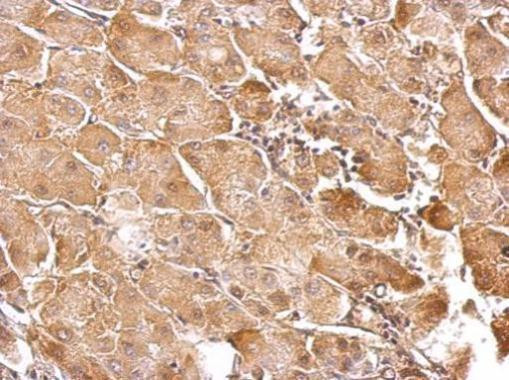
GSTT1 Antibody in Immunohistochemistry (Paraffin) (IHC (P))

Search
Invitrogen
GSTT1 Polyclonal Antibody
{{$productOrderCtrl.translations['antibody.pdp.commerceCard.promotion.promotions']}}
{{$productOrderCtrl.translations['antibody.pdp.commerceCard.promotion.viewpromo']}}
{{$productOrderCtrl.translations['antibody.pdp.commerceCard.promotion.promocode']}}: {{promo.promoCode}} {{promo.promoTitle}} {{promo.promoDescription}}. {{$productOrderCtrl.translations['antibody.pdp.commerceCard.promotion.learnmore']}}
图: 1 / 5
GSTT1 Antibody (PA5-22011) in IHC (P)





产品信息
PA5-22011
种属反应
宿主/亚型
分类
类型
抗原
偶联物
形式
浓度
规格
纯化类型
保存液
内含物
保存条件
运输条件
RRID
产品详细信息
Recommended positive controls: HepG2, mouse spleen, rat liver.
Predicted reactivity: Mouse (81%), Rat (80%), Rhesus Monkey (97%), Bovine (86%).
Store product as a concentrated solution. Centrifuge briefly prior to opening the vial.
靶标信息
Glutathione S-transferase (GST) theta 1 (GSTT1) is a member of a superfamily of proteins that catalyze the conjugation of reduced glutathione to a variety of electrophilic and hydrophobic compounds. Human GSTs can be divided into five main classes: alpha, mu, pi, theta, and zeta. The theta class includes GSTT1 and GSTT2. The GSTT1 and GSTT2 share 55% amino acid sequence identity and both of them were claimed to have an important role in human carcinogenesis. The GSTT1 gene is located approximately 50kb away from the GSTT2 gene. The GSTT1 and GSTT2 genes have a similar structure, being composed of five exons with identical exon/intron boundaries.
仅用于科研。不用于诊断过程。未经明确授权不得转售。
篇参考文献 (0)
生物信息学
蛋白别名: Glutathione S-transferase 1 (theta); Glutathione S-transferase 5; Glutathione S-transferase theta-1; Glutathione transferase T1-1; GST 5-5; GST class-theta-1; GSTT1
基因别名: AI255817; GSTT1; Gstt1-1; GSTYRS
UniProt ID: (Human) P30711, (Rat) Q01579, (Mouse) Q64471
Entrez Gene ID: (Human) 2952, (Rat) 25260, (Mouse) 14871